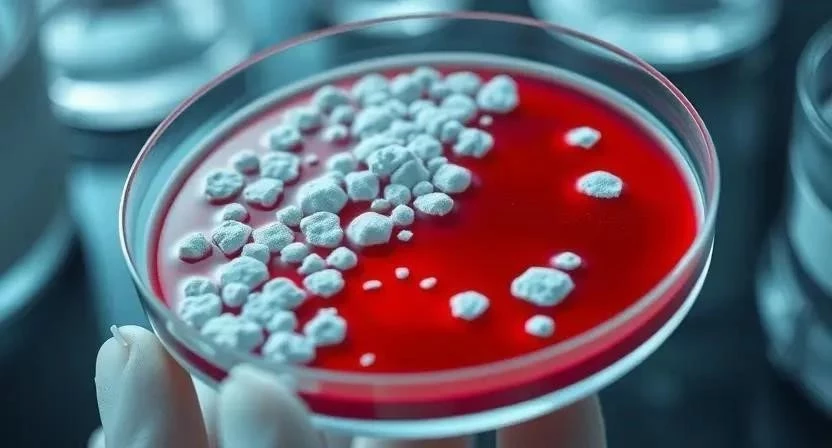

Беспокоитесь о здоровье своего ребенка и хотите знать, как защитить его от серьезных инфекций? Дифтерия – это острое инфекционное заболевание, которое может привести к тяжелым осложнениям. Важно уметь распознать первые признаки и знать, как действовать. По данным статистики, дифтерия остается проблемой общественного здравоохранения во многих странах, несмотря на наличие эффективной вакцинации. Ключевым моментом является своевременная диагностика и лечение, которые позволяют избежать серьезных последствий. Давайте разберемся, что нужно знать о дифтерии у детей.
О методике: Суть инфекционного процесса
Дифтерия вызывается бактерией Corynebacterium diphtheriae, также известной как палочка Леффлера. Инфекция распространяется воздушно-капельным путем, при контакте с больным человеком или носителем бактерии. Основную опасность представляет собой токсин, вырабатываемый бактерией, который поражает сердце, нервную систему и почки. Токсин распространяется по всему организму через кровь, вызывая воспаление и повреждение тканей. Именно действие токсина определяет тяжесть заболевания и риск развития осложнений.
Для кого подходит: Группы риска
Наиболее уязвимы к дифтерии дети в возрасте от 2 до 5 лет, особенно те, которые не были вакцинированы или не получили полную вакцинацию согласно календарю прививок. Группы риска включают детей, посещающих детские сады и школы, а также детей с ослабленным иммунитетом. Пути передачи инфекции – это в основном капли слюны при кашле, чихании или разговоре с больным человеком. Факторы, способствующие заражению, включают скученность, плохую вентиляцию и недостаточную гигиену.
Принципы методики: Основы диагностики
Диагностика дифтерии включает в себя клинический осмотр, сбор анамнеза и лабораторные исследования. Ключевым методом является бактериологический анализ мазка из зева, который позволяет выявить наличие бактерии Corynebacterium diphtheriae. Также проводится определение токсигенности бактерий, то есть способности вырабатывать токсин. Для подтверждения диагноза могут быть использованы дополнительные методы, такие как иммунохроматографический анализ и полимеразная цепная реакция (ПЦР).
Необходимые материалы: Медикаменты и инструменты
Для диагностики дифтерии необходимы стерильные инструменты для взятия мазка из зева, транспортная среда для сохранения образца, реактивы для бактериологического анализа и ПЦР. Для лечения используются антитоксические сыворотки, антибиотики (обычно пенициллин или эритромицин), а также препараты для поддержания функции сердца и дыхательной системы. В стационаре может потребоваться кислородная терапия, искусственная вентиляция легких и другие реанимационные мероприятия.
Пошаговый план: Алгоритм действий при подозрении на дифтерию
При подозрении на дифтерию необходимо немедленно обратиться к врачу. Алгоритм действий включает следующие этапы:
| Этап | Действие | Срок | Результат |
|---|---|---|---|
| 1 | Вызов врача на дом или немедленная госпитализация | Немедленно | Изоляция больного, начало диагностики |
| 2 | Взятие мазка из зева для бактериологического анализа | В течение 1 часа | Подтверждение или исключение диагноза |
| 3 | Немедленно после подтверждения диагноза | Нейтрализация токсина | |
| 4 | Начало антибактериальной терапии | Немедленно после подтверждения диагноза | Уничтожение бактерий |
| 5 | Интенсивная терапия при развитии осложнений | По мере необходимости | Поддержание жизненно важных функций |
Упражнения и практика: Режим покоя и восстановление
В период болезни и после выздоровления ребенку необходим строгий постельный режим и полноценное питание. При дифтерийном крупе важно обеспечить проходимость дыхательных путей, используя увлажненный воздух, ингаляции и, при необходимости, бронхолитики. После выписки из стационара рекомендуется постепенное увеличение физической активности и соблюдение диеты, богатой витаминами и минералами. Я помню, как мой племянник тяжело перенес дифтерию, и ему потребовалось несколько месяцев для полного восстановления сил.

Проверка прогресса: Контрольные мазки и выписка
Для контроля эффективности лечения проводятся контрольные мазки из зева для выявления бактерий. Критерии выписки из стационара включают отсутствие признаков интоксикации, нормализацию температуры тела, отрицательные результаты контрольных мазков и отсутствие признаков осложнений. После выписки ребенок должен находиться под наблюдением педиатра в течение нескольких месяцев для своевременного выявления возможных рецидивов или осложнений. В моей практике был случай, когда у ребенка после выписки развился миокардит, и ему потребовалось дополнительное лечение.
Частые ошибки: Опасность самолечения и отказ от вакцинации
Одной из самых распространенных ошибок является самолечение дифтерии под маской ангины. Это может привести к задержке в начале адекватной терапии и развитию тяжелых осложнений. Отказ от госпитализации также является серьезной ошибкой, так как только в стационаре можно обеспечить необходимый уровень медицинской помощи. Несвоевременная вакцинация – это еще одна распространенная ошибка, которая увеличивает риск заражения дифтерией. Я всегда подчеркиваю родителям важность соблюдения календаря прививок.
Советы для эффективности: Укрепление иммунитета и гигиена
Для профилактики дифтерии необходимо соблюдать календарь прививок, регулярно проводить влажную уборку в помещении, проветривать помещение и соблюдать правила личной гигиены. Важно укреплять иммунитет ребенка, обеспечивая ему полноценное питание, достаточный сон и регулярные физические нагрузки. Я всегда советую своим пациентам избегать контакта с больными людьми и соблюдать карантинные мероприятия при возникновении вспышек дифтерии.
Сроки результата: Инкубационный период и выздоровление
Инкубационный период дифтерии составляет от 2 до 5 дней. Сроки выздоровления зависят от тяжести заболевания и своевременности начала лечения. В легких случаях выздоровление наступает через 2-3 недели, в тяжелых случаях – через несколько месяцев. Формирование иммунитета после перенесенной инфекции непродолжительное, поэтому необходимо поддерживать иммунитет с помощью ревакцинации.
Альтернативные методы: Дифференциальная диагностика
Дифтерию необходимо дифференцировать от других заболеваний, таких как ложный круп и тонзиллит. В таблице ниже представлены основные различия между этими заболеваниями:
| Признак | Дифтерия | Ложный круп | Тонзиллит |
|---|---|---|---|
| Налет в горле | Плотный, трудноудаляемый | Слизистый, легкоудаляемый | Гнойный |
| Отек шеи | Выраженный | Умеренный | Отсутствует |
| Температура тела | Умеренно повышенная | Высокая | Повышенная |
| Общее состояние | Тяжелое | Тяжелое | Умеренно тяжелое |
FAQ: Популярные вопросы о дифтерии
1. Какие симптомы дифтерии у детей? Основные симптомы включают боль в горле, налет в горле, отек шеи, лихорадку и слабость.
2. Какие осложнения могут возникнуть при дифтерии? Осложнения включают миокардит, полиневрит, почечную недостаточность и дыхательную недостаточность.
3. Какие побочные эффекты могут быть после прививки от дифтерии? Побочные эффекты обычно легкие и включают покраснение и болезненность в месте инъекции, а также небольшое повышение температуры тела.
4. Как долго длится инкубационный период дифтерии? Инкубационный период составляет от 2 до 5 дней.
5. Как лечить дифтерию? Лечение включает введение антитоксической сыворотки и антибиотиков.
6. Можно ли заразиться дифтерией повторно? Да, можно, так как иммунитет после перенесенной инфекции непродолжительный.
7. Что делать, если у ребенка появились симптомы дифтерии? Немедленно обратиться к врачу.
Я надеюсь, что эта информация поможет вам лучше понять дифтерию и принять меры для защиты здоровья вашего ребенка. Помните, что своевременная диагностика и лечение – это ключ к успешному выздоровлению. Не стесняйтесь обращаться к врачу при любых подозрениях на инфекцию.




